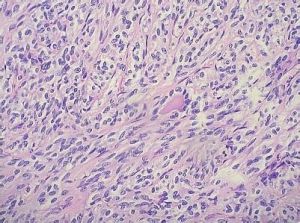
梭形細胞腫瘤 梭形細胞腫瘤

介紹
梭形細胞腫瘤主要是以梭形細胞為主,可發生在任何器官或組織,形態學表現可以是癌也可以是瘤。如發生在上皮組織(如梭形細胞癌、梭形細胞鱗癌),也可以發生在間葉組織(如梭形細胞肉瘤,梭形細胞間質肉瘤),形態表現複雜,多類似肉瘤,或伴有形似肉瘤的間質成份,免疫表型既可表現為癌,也可表現為肉瘤,或表現為癌肉瘤結構等的一類腫瘤。該病變較難直接檢查,需多方面的檢測如免疫組織化學標記等。
上皮性梭形細胞腫瘤
梭形細胞癌有時由於非上皮性標記物表達,較易誤診為肉瘤。
間葉性梭形細胞腫瘤
間葉組織的梭形細胞腫瘤有時細胞角蛋白表達,需與上皮來源的癌進行鑑別。
梭形細胞癌肉瘤
有時單靠細胞角蛋白表達易誤診為癌。需結合臨床,病變部位,組織形態學特徵,綜合分析才能明確診斷。
惡性中胚葉混合瘤與子宮內膜間質肉瘤
由梭形細胞構成的惡性中胚葉混合瘤(癌肉瘤)與子宮肉膜間質肉瘤,免疫組化角蛋白與波形蛋白都可表達,應注意鑑別。
胃腸道或胃腸道外間質腫瘤
胃腸道或胃腸道外間質腫瘤,瘤細胞形態主要為梭形細胞,上皮樣細胞或混合細胞形式出現。胃腸梭形細胞腫瘤易被誤診為GIST(胃腸間質瘤)。
病理分析
以梭形細胞為主的腫瘤類型很多,除肉瘤外還有一些癌和惡性黑色素瘤:當細胞分化程度低時,進行組織類型診斷常較困難。在觀察切片進行鑑別診斷時,可以從以下幾方面入手,逐層剖析。 (1)首先從腫瘤發生的部位和病人年齡出發,初步分析肉瘤、癌或惡性黑色素瘤何者可能性大。低分化的軟組織肉瘤和惡性外周神經腫瘤多發生於人體較深部的組織,肌肉、腹膜後、盆腔、縱隔和內臟器官,與組織表面被覆的皮膚或黏膜上皮關係不密切、低分化的梭形細胞癌多見於被覆鱗狀上皮或移行上皮的器官組織如鼻咽、食管、膀胱,腫瘤與上皮關係密切,有潰瘍形成。此外,肺、甲狀腺等器官內也可見梭形細胞癌。惡性黑色素瘤則多見於皮膚及外胚層來源的黏膜。對兒童和20歲以下的青少年多考慮肉瘤,成年人則肉瘤和癌都有可能。
(2)軟組織腫瘤中出現較多瘤巨細胞和奇形細胞者一般不是纖維肉瘤,而應多考慮橫紋肌肉瘤、脂肪肉瘤、惡性纖維組織細胞瘤或平滑肌肉瘤,其次惡性周圍性神經鞘腫瘤。
(3)梭形細胞的形態和排列方式可以在一定程度上提供腫瘤組織類型的線索。例如纖維肉瘤細胞的胞質通常不如肌源性細胞豐富,胞質寬度一般不超過核的寬度,細胞邊界也不如後者的清楚;而肌源性腫瘤細胞可呈長梭形或帶狀.胞質內可見縱行的原纖維,橫紋肌肉瘤的胞質嗜伊紅染色較強。纖維肉瘤的梭形細胞束多呈人字形排列;車輻狀結構多見於惡性纖維組織細胞瘤,其他梭形細胞性肉瘤中亦可見,但較少且不甚典型。核柵狀排列在惡性神經鞘膜瘤和中度分化的平滑肌肉瘤中雖不如相應的良性腫瘤中明顯,但仍有時可見。
(4)仔細尋找梭形細胞向其他形態細胞過度的證據;以梭形細胞為主的肉瘤中如果能找到向橫紋肌母細胞、脂肪母細胞等方向分化過度,或者呈雙向分化(滑膜肉瘤、惡性間皮瘤),則依分化方向作分類診斷。
(5)經過上述分析,鑑別腫瘤類型仍有困難時可藉助免疫組化、特殊染色或電鏡檢查。